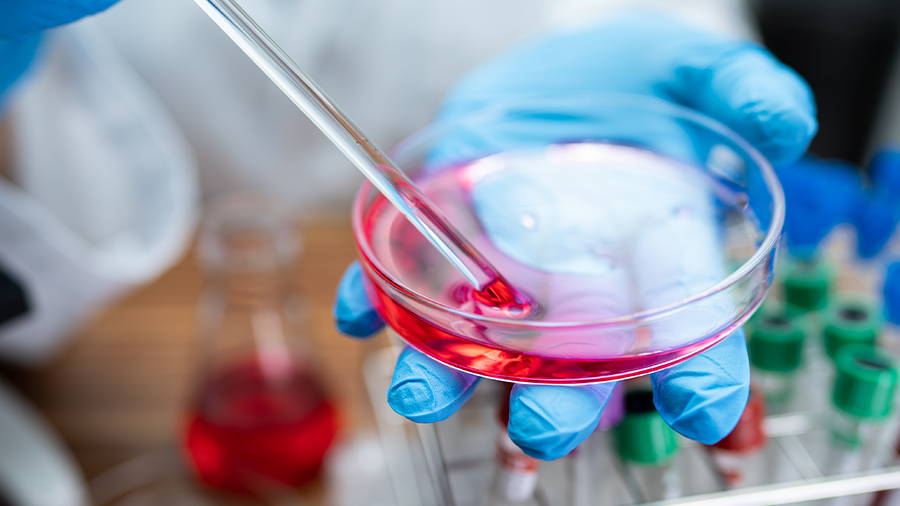

We have a comprehensive inventory of food safety testing standards for food nutrients, food additives, pesticides, veterinary drugs, toxins, etc., as well as thousands of reference standards for environmental safety, pharmaceutical metabolites & impurities, traditional Chinese medicine active ingredients & natural products, clinical testing, stable isotope labeling, pure compounds in chemical industry, etc.
Your Trusted Partner for Reference Materials
Lab Consumables
Customized Mix Standard Solutions
With over 30,000 reference standards in stock, A Chemtek has a wide selection of compounds to produce customized mixes that are cost-effective with short lead times.
Creating customized mixes is a collaborative process to develop a uniquely tailored product to align with your exact needs. With over 15 years of experience, our team is committed to working closely with you and providing support along every step of the way!